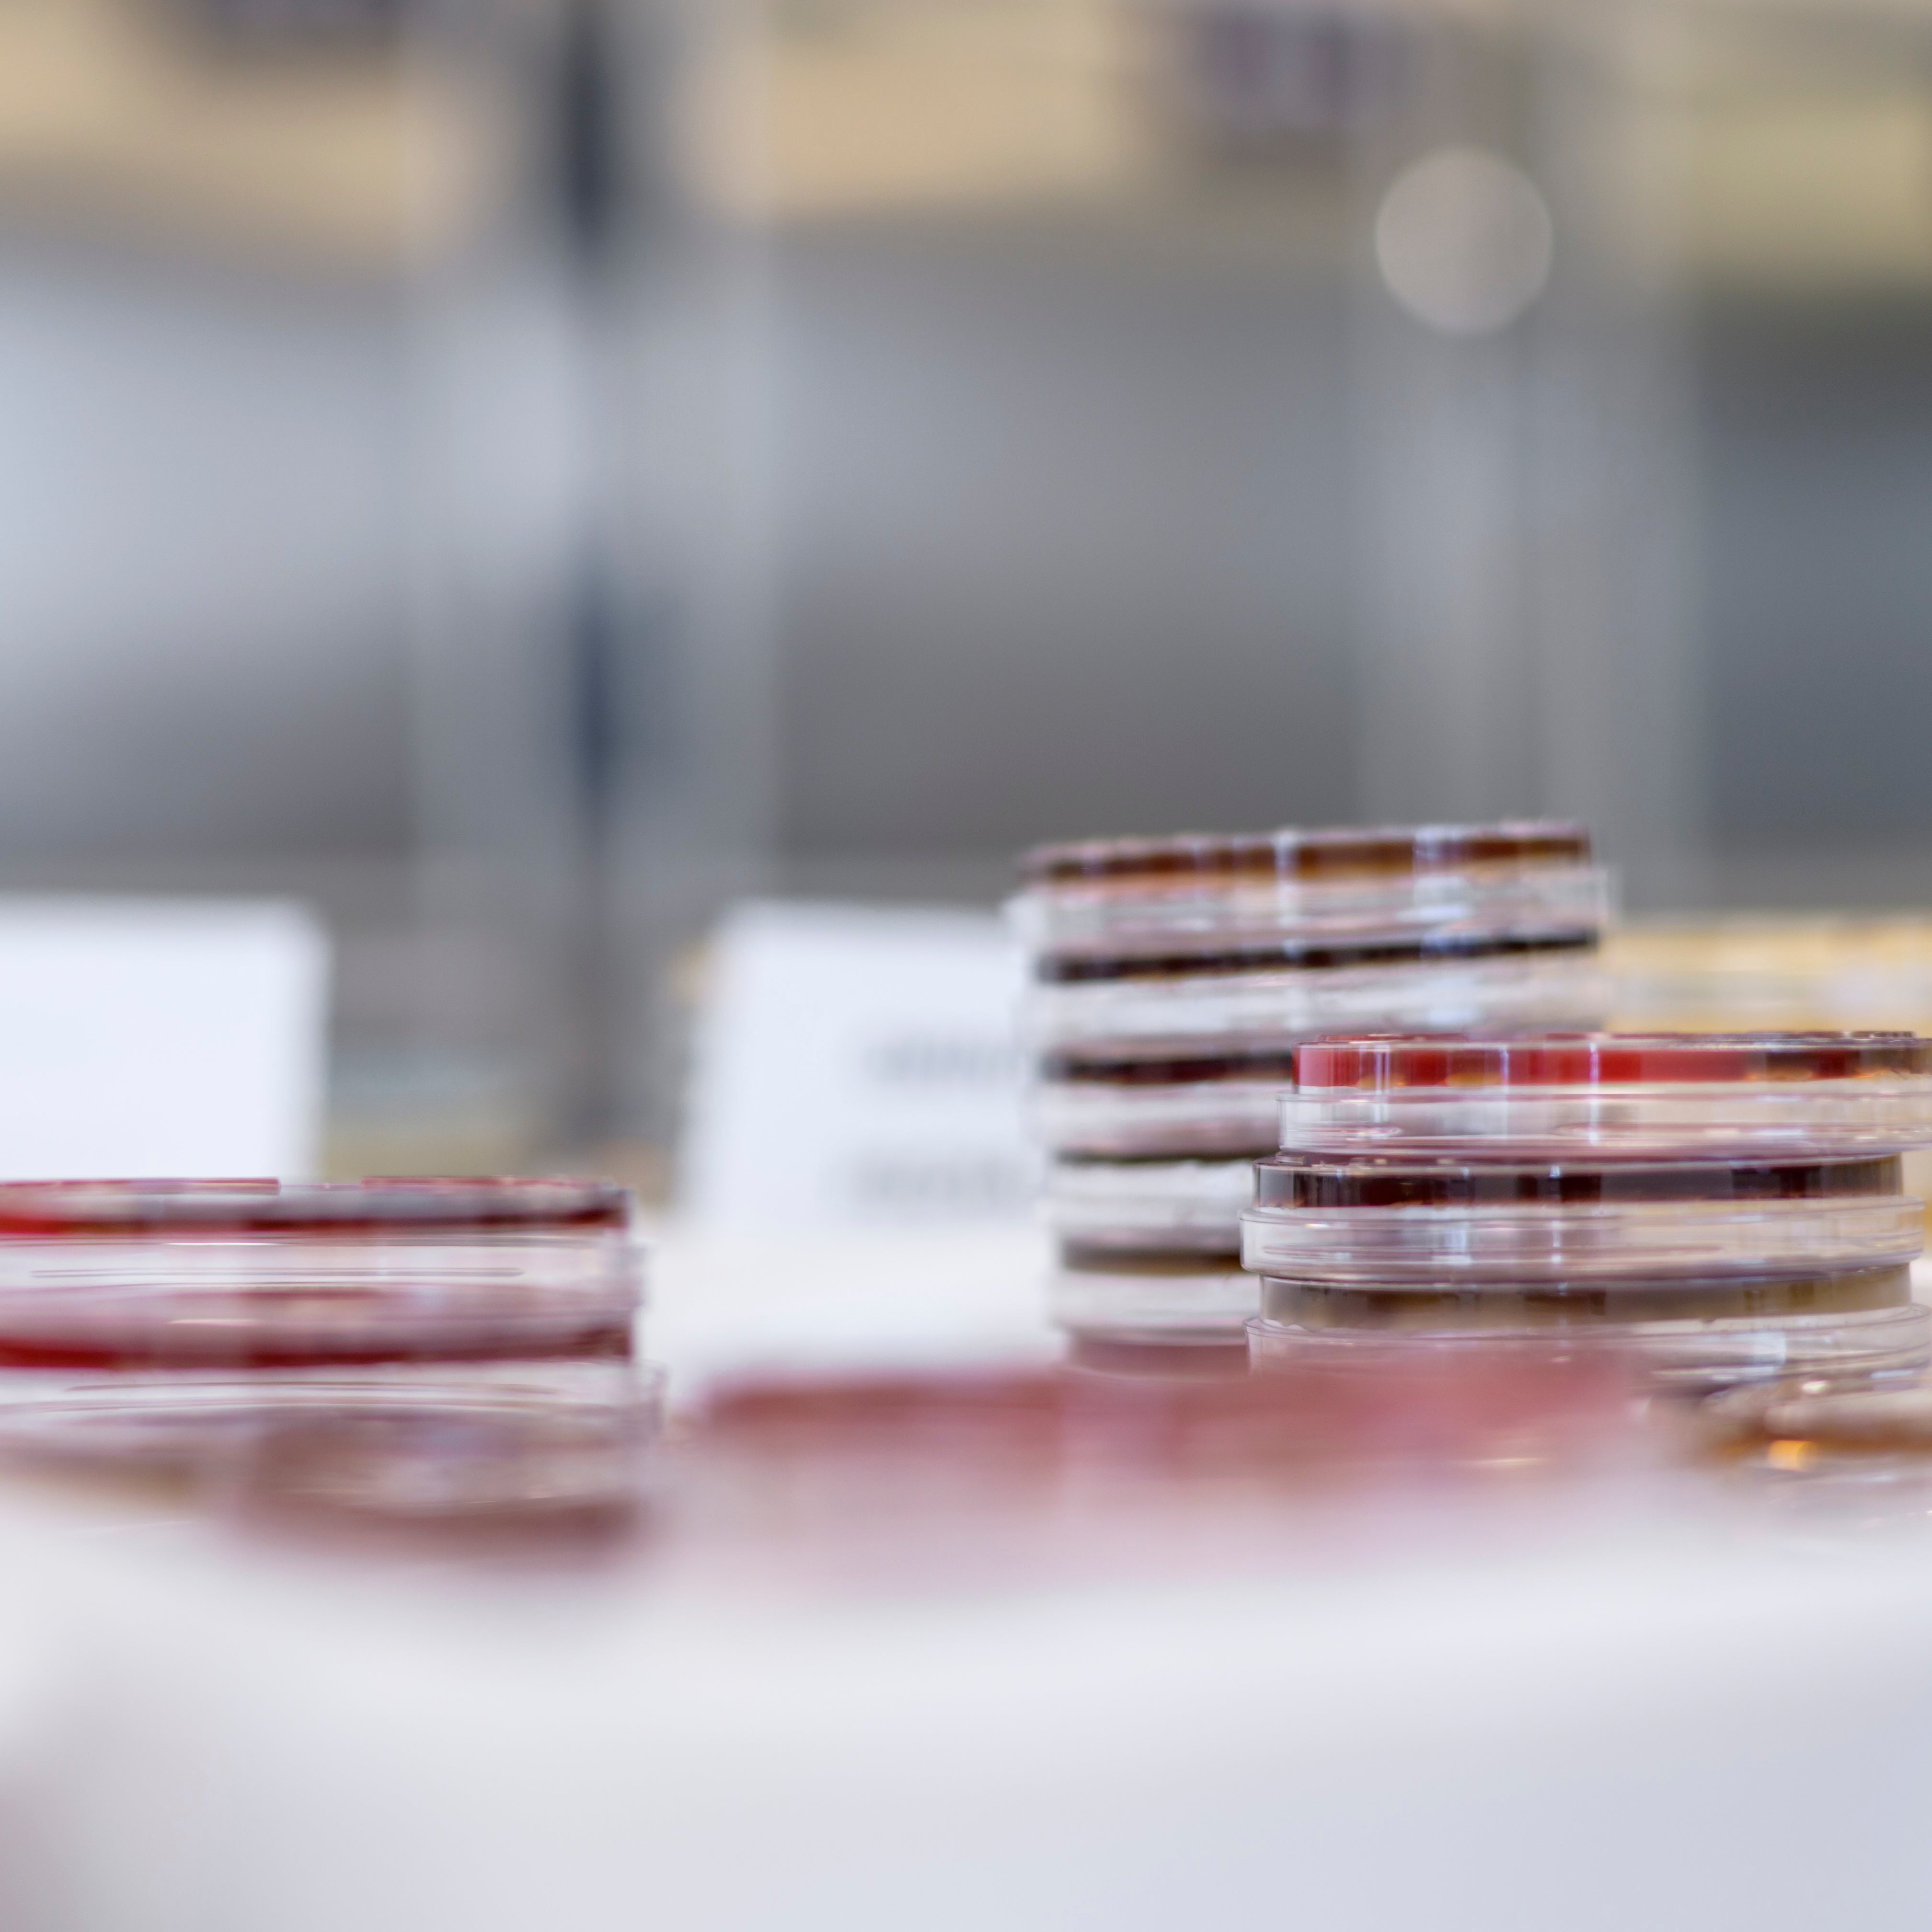

Sistema automatitzat d'identificacions (espectrometria de masses maldi-tof)
Sistema automatitzat d'antibiogrames
Sistema automatitzat d'hemocultius
Bacteriologia
- Cultius bacterians
- Cultiu Helicobacter pylori
- Estudi de detecció de gèrmens multiresistents
- Estudi de portadors (manipuladors d'aliments, etc.)
- Tinció de Gram
- Tinció d'Encre Xinesa
Micologia
- KOH (visualització directa)
- Cultiu de fongs (pell, cabell, ungles…)
Micobacteris
- Cultiu en medi líquid (Sistema automatitzat)
- Cultiu en medi sòlid (Lowenstein-Jensen)
- Tinció de Zhiel-Neelsen
Parasitologia
- Identificació de paràsits humans (excrements, orina, pèl, pell, etc.)
- Cultiu de paràsits (acanthamoeba, leishmania)
- Tinció de Giemsa
Detecció d’antígens i toxines
- Helicobacter pylori
- Clostridium difficille
- Clostridium perfringens
- Legionella
- Streptococcus pneumoniae
- Streptococcus pyogenes (Grupo A)
- Rotavirus
- Adenovirus
- Astrovirus
Sang a les femtes
- Test de la bencidina
- Test immunocromatogràfic (anticossos monoclonals)
Detecció d’antígens i toxines
- Helicobacter pylori
- Clostridium difficille
- Clostridium perfringens
- Legionella
- Streptococcus pneumoniae
- Streptococcus pyogenes (Grupo A)
- Rotavirus
- Adenovirus
- Astrovirus